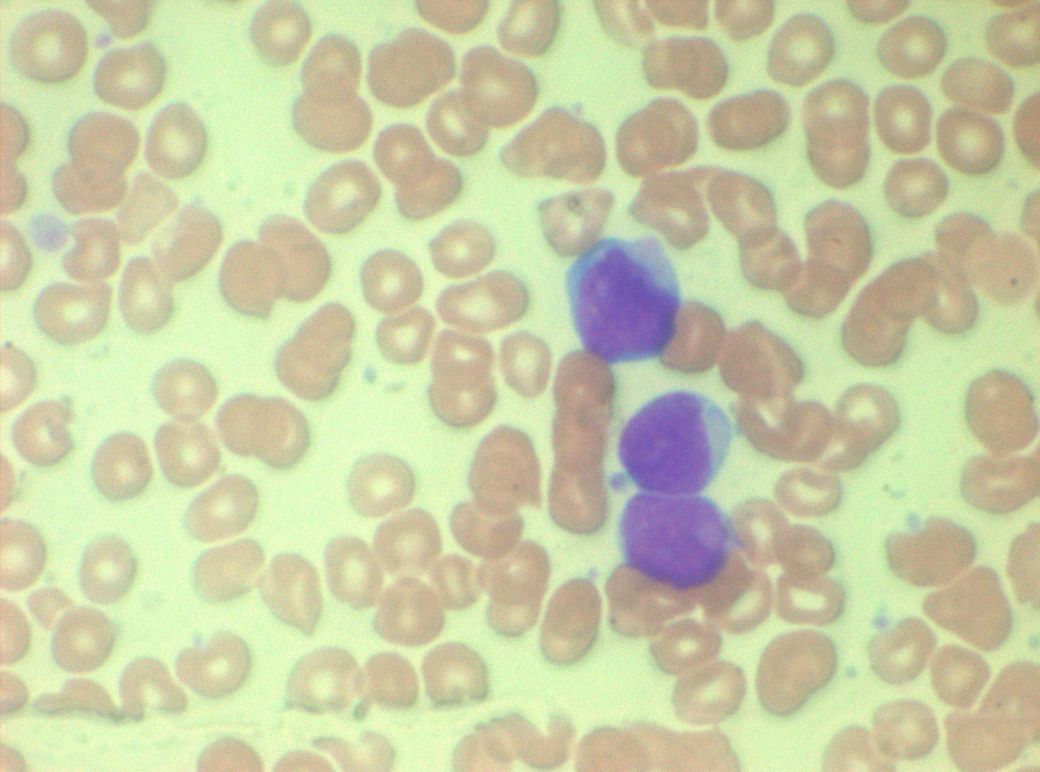
AML, Blutbild

zurück
Home |
AML
akute myeloische Leukämie |

peripheres Blutbild |
Allgemeines |
AMLs sind klonale Entartungen von
Knochenmarksstammzellen. |
Epidemiologie |
BRD: mit 4/100.000 Einwohner/Jahr
etwas häufiger als die ALL. Mittleres Alter 70a. |
Prognose |
Unbehandelt Überlebenszeit 3 Monate.
Ungünstig:
- > 60a
- sekundäre AML
- komplexe Aberrationen
- FLT-3 positiv
- jüngeren Patienten: 5a-OS 30 - 40%
- > 60a: 5a-OS 15%
|
Überlebensrate von 7652 Männern
und 6488 Frauen mit AML. SEER-Datenbank 2013.
 |
Einteilung (1) |
- niedrig maligne: APL
- intermedial maligne
- hoch maligne
|
WHO - Einteilung
- Typ 1: AML mit spezifischen zytogenetischen Translokationen
- Typ 2: AML mit multilinärer Dysplasie (2-3 Linien betreffend)
- Typ 3: Therapie-induzierte AML mit myelodysplastischem Syndrom
- Typ 4: andere AML-Formen
|
Mito-AML:(2)
hohe Anzahl an Mitochondrien-Proteinen,
neu organisierten Mitochondrien-Stoffwechsel
Resistenz gegenüber Chemotherapie
Therapie: BCL2-Inhibitor Venetoclax |
Klinik |
Hepatosplenomegalie durch diffuse
Infiltration. Gingivitis. Lymphknotenschwellungen selten! |
Staging |
Diagnostik |
Zytochemie: Peroxydase (POX), Esterase |
Morphologie |
Atypische Myeloblasten im Blut:
großer Kern, wenig Zytoplasma. |
AUER-Stäbchen: lysosomale Abbauprodukte,
Peroxidase-positiv. |
Knochenmark: Verdrängung der Erythropoese und Megakaropoese
durch leukämische Infiltrate. Diagnosesicherung: 25% Blasten in Knochenmark oder
Blut. Auer-Stäbchen |
Molekularbiologie |
90% exprimieren CDX2. Diese blockiert
KLF4. PPARγ-Agonisten hemmen CDX2 indem sie die KLF4-Synthese steigern. |
Zytogenetik |
Risikoklassifikation,
FLT3-ITD-Mutation |
Therapie |
Jüngere fitte Patienten: intensive Induktionschemotherapie, dann konsolidierende Chemotherapie, allogene Stammzelltransplantation (HSCT)
|
Ältere Patienten werden meistens mit
Daunorubizin - Cytarabin behandelt. 40-50% erzielen eine komplette Remission.
Induktion: Daunorubizin Tag 1-3, Cytarabin Tag 1-7 |
Chemotherapie |
Remissions-Induktions-Strategie |
intensive Chemotherapie:
Cytarabin 2x 3 g/qm (1 g/qm > 60 Jahren) d1-d3
Mitoxantron 10 mg/qm d3-d5
12d Konditionierungstherapie, dann
ASZ |
offene Protokolle |
In Deutschland gibt es 4 bedeutende
Studiengruppen: AMLCG, SHG Dresden, HD Ulm, OSHO Leipzig
RATIFY: Midostaurin in der Primärbehandlung der FTL3 positiven AML.
BLAST-Studie |
Ergebnisse |
AML-BFM-98 (Kinder: Münster, Jena, Wien) |
Rest |
Bei Aktivierung der Tyrosinkinase
FLT3 kann der Kinase-Inhibitor Midostaurin eingesetzt werden. |
Teil von |
Leukämie |
Maligne Systemerkrankungen |
spezielle Tumoren |
Onkologie |
Quellen |
1.) Swerdlow SH, Campo E, Harris NL, et al., eds.:
WHO classification of tumours of haematopoietic and lymphoid tissues.
Lyon, France: IARC Press, 2008.
2.) Jayavelu A K, et al:
The proteogenomic subtypes of acute myeloid leukemia.
Cancer Cell 2022;40 (3):301-317
DOI:https://doi.org/10.1016/j.ccell.2022.02.006
|
 |